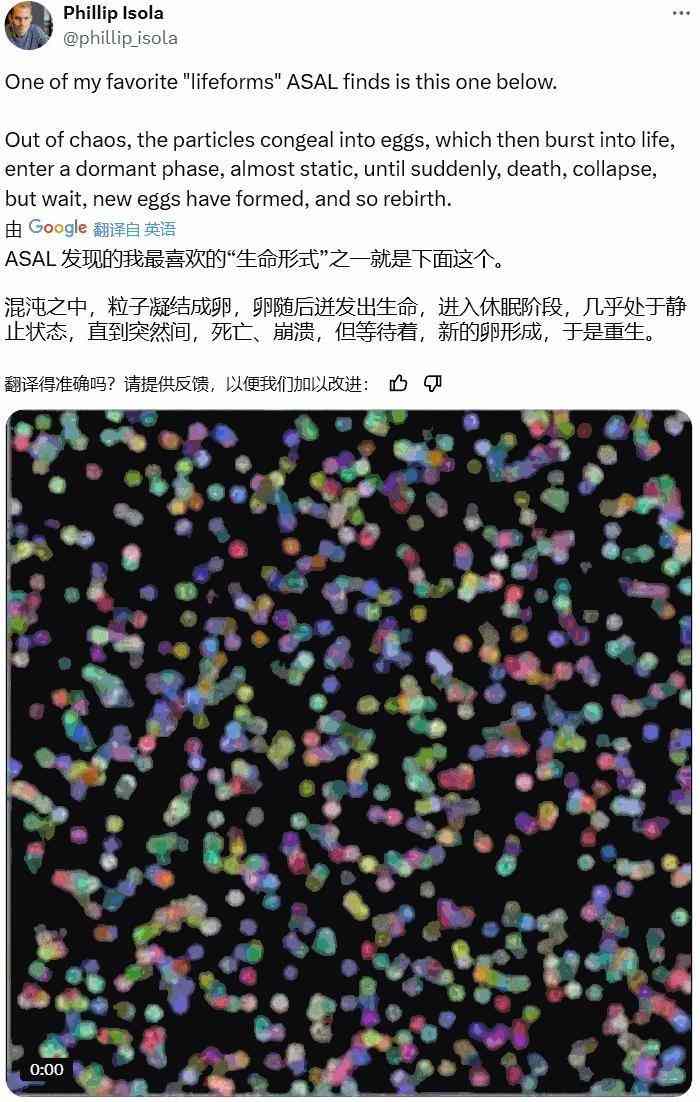
AI首次自主发现人工生命，“上帝造物”的秘密要揭开了？(图3)

AI首次自主发现人工生命,“上帝造物”的秘密要揭开了?
近日,人工智能领域迎来了一项革命性的突破。Transformer 论文作者之一的 Llion Jones 与前谷歌研究人员 David Ha 共同创立的人工智能公司 Sakana AI,联合MIT、OpenAI、瑞士AI实验室IDSIA等机构的研究人员,共同提出了一种名为“自动化人工生命搜索”( Automated Search for Artificial Life, ASAL)的新算法。

这一创新技术使得AI能够自主发现全新的人造生命体,而无需繁琐的手工设计过程,标志着人工生命(Artificial Life, ALife)研究迈入了一个全新的里程碑。
什么是人工生命?
人工生命听起来很科幻,最早源于数学家约翰・何顿・康威在 1970 年提出的著名的“生命游戏”便是一种模拟人工生命系统,其中定义的规则可让其中的“细胞”像生命体一样运作。
人工生命是一个跨学科领域,结合了计算科学、生物学、复杂系统科学以及物理学等多个领域的知识,致力于研究生命的本质及其起源、演化和行为。它旨在通过模拟生命的行为、特性和演化过程来理解生命的本质,探索的范围不仅限于地球上的生物形式,还包括可能的外星生命或完全虚构的生命形式。
下图为 ASAL 其中一位作者 Phillip Isola 的推文以及他分享的一种人工生命。

通过计算机模拟,科学家们正在探索一个更宏大的命题——可能存在的生命形式。然而,过去的人工生命模拟往往依赖于复杂的手工设计,每一个细微的规则都需要研究者精心制定。这不仅限制了研究的效率,也阻碍了新生命形式的发现。
ALife的研究揭示了推动和加速人工智能进步的重要洞见,特别是对于涌现现象、进化机制和智能本质的理解。如果用AI加速人工生命的发现,人类就能更好地理解这些核心原则,从而启发未来的AI系统。
ASAL算法的创新之处
ASAL算法的出现,彻底改变了这一现状。该算法利用三种视觉-语言基础模型,能够自动搜索并发现模拟空间中最有趣、最具开放式的人造生命体:

- 监督式目标搜索(Supervised Target):搜索能产生指定目标事件或事件序列的模拟,有助于发现任意世界或与我们自己的世界相似的世界。
- 开放式搜索(Open-Endedness):在基础模型的表征空间中搜索会随时间不断提供新变化的模拟,由此可以发现对人类观察者来说总是很有趣的世界。
- 阐明(Illumination)搜索:搜索一组相关的多样化模拟,从而展现对我们来说非常陌生的世界。
人工生命基质(substrate),记为 S,其包含任何一组相关的人工生命模拟(例如,所有 Lenia 模拟的集合)。这些模拟可能在初始状态、转换规则或两者上有所不同。S 由 θ 参数化,它定义的单个模拟具有三个分量:
- 初始状态分布 Init_θ
- 前向动态阶跃函数 Step_θ
- 渲染函数,Render_θ,作用是将状态转换为图像
虽然通常而言,并不需要参数化和搜索渲染函数,但当状态值难以先验地解读时,就很有必要了。将这些项串到一起,可定义一个 θ 函数,它对初始状态 s_0 进行采样,运行 T 步模拟,并将最终状态渲染为图像:

最后,还有另外两个函数 VLM_img (・) 和 VLM_txt (・),它们的作用是通过视觉 – 语言基础模型嵌入图像和自然语言文本,以及相应的内积 ⟨・,・⟩,以促进该嵌入空间的相似性测量。
监督式目标
人工生命的一个重要目标是找到能让所需事件或事件序列发生的模拟。这样的发现将使研究者能够找到与我们自己的世界相似的世界,或测试某些反事实的进化轨迹在给定基质中是否可能,从而深入了解某些生命形式的可行性。
为此,ASAL 会搜索一种模拟,该模拟会产生与基础模型表示中的目标自然语言相匹配的图像。研究者可以控制在每个时间步骤应用哪个提示(如果有的话)。

开放式
人工生命的一大挑战是寻找开放式模拟。找到这样的世界才能复现现实世界中永无止境的有趣新奇事物的爆发。
尽管开放性是主观的且难以定义,但正确表示空间的新颖性(novelty)可以体现开放性的一般概念。这样一来,可将测量开放性的主观性外包给表征函数的构建。在本文中,视觉 – 语言基础模型表征充当了人类表征的代理。

阐明
人工生命的另一个关键目标是自动阐明不同现象构成的整个空间,而这些现象是从基质涌现出来的。基于此,可以让我们了解「生命的可能模样」。因此,阐明是描绘和分类整体基质的第一步。
为了实现这一目标,ASAL 会搜索一组模拟并且这些模拟产生的图像与基础模型表征中的最近邻相距甚远。该团队发现最近邻多样性比基于方差的多样性能实现更好的阐明。

研究者只需定义模拟空间的搜索范围,ASAL便能自动探索出各种新奇的生命形式。

ASAL算法的创新之处在于其将基础模型应用于人工生命模拟搜索,自动化了规则设计和现象探索的过程。这不仅促进了新型人工生命体的自动发现,还为复杂性和开放性等现象提供了新的分析工具。研究者表示,通过利用AI加速人工生命的发现,我们可以加速对涌现、进化和智能的理解——这些核心原则将启发下一代AI系统的发展。
此外,ASAL算法的应用还具有深远的意义。它不仅推动了人工生命研究的进步,还为探索可能存在的生命形式提供了新的途径。通过计算机模拟,科学家们可以探索更宏大、更复杂的生命现象,从而加深对生命本质的理解。
实验验证ASAL真的可以
在实验中,ASAL算法展现了其强大的搜索能力。研究人员利用Boids、Particle Life、生命游戏(Game of Life)、Lenia和神经元胞自动机(Neural Cellular Automata)等多种人工生命基质,验证了ASAL的有效性。
- Boids:模拟的是 N 个「鸟状物体(boids)」在 2D 欧几里得空间中的移动情况。所有 boids 都共享权重一样的神经网络,其会根据局部参考系中 K 个近邻 boids 向左或向右操纵每个 boid。该基质是神经网络的权重空间。
- 粒子生命:模拟 N 个粒子,这些粒子又可分为 K 类;它们在一个 2D 欧几里得空间运动。该基质是 K × K 相互作用矩阵的空间,β 参数确定了粒子之间的距离。初始状态是随机采样的,粒子会自组织形成动态模式。
- 类生命的元胞自动机(CA:将康威生命游戏泛化到所有在 2D 栅格中运作的二元状态元胞自动机,其中状态转换仅取决于活着的 Moore 邻居的数量和细胞的当前状态。该基质有 2^18 = 262,144 种可能的模拟。
- Lenia:将康威生命游戏推广到连续空间和时间,允许更高的维度、多个核和多个通道。该团队使用了 LeniaBreeder 代码库,它定义了基质,其中动态维度为 45 个,初始状态维度为 32 × 32 × 3 = 3,072 个。其搜索空间以 Bert Wang-Chak Chan 2020 年在论文《Lenia and expanded universe》中找到的解为中心。
- 神经元胞自动机(NCA):通过神经网络表示局部转换函数来参数化任何连续元胞自动机。该基质是神经网络的权重空间。
在每种基质中,ASAL都发现了以前从未见过的生命形式,并扩展了人工生命中涌现结构的边界。
搜索目标模拟
其中包括单个目标和随时间变化的目标序列。
对于单个目标,以下动图定性地展示 ASAL 的良好效果,可以找到与指定提示词匹配的模拟。

对于时间目标,下图表明可以找到能产生遵循一系列提示词的轨迹的模拟。通过指定所需的进化轨迹并使用约束基质,ASAL 可以识别体现所需进化过程本质的更新规则。例如,当提示词序列为「一个细胞」然后是「两个细胞」时,相应的更新规则本质上就是实现自我复制。

搜索开放式模拟
下图(Fig.5) 展示了 ASAL 在类生命元胞自动机的开放式模拟中的潜力。

根据 3 式中的开放式指标,著名的康威生命游戏位列最开放的元胞自动机(CA)的前 5%。
Fig.5a 表明,最开放的 CA 表现了处于混沌边缘的非平凡动态模式,因为它们既没有稳定也没有爆发。
Fig.5b 则描绘了三个 CA 在 CLIP 空间中随模拟时间的轨迹。由于基础模型的表征与人类表征相关,因此通过基础模型的表征空间在轨迹中产生新颖性也会为人类观察者产生一系列新颖性。
Fig.5c 则可视化了所有类生命元胞自动机,从中可以看到涌现出的有意义的结构:最开放的 CA 紧密地靠在模拟主岛外的一个小岛上。
阐明整体基质
该团队使用了 Lenia 和 Boids 基质来研究公式 4 中的阐明算法的有效性。基础模型是 CLIP 。他们定制了一个用于搜索的遗传算法:在每一代,随机选择父母,创建变异的孩子,然后保留最多样化的解子集。
下面的 2 个「Simulation Atlas」展示了生成的模拟集。


此可视化凸显了按视觉相似性组织的行为的多样性。使用 Lenia 时,ASAL 发现了许多前所未见的生命形式,这些生命形式类似于按颜色和形状组织的细胞和细菌。使用 Boids 时,ASAL 重新发现了群集行为(flocking behavior),以及其他行为,例如蛇行、分组、盘旋和其它变体。
量化人工生命
基础模型不仅有助于搜索有趣现象,而且还可以量化以前只能进行定性分析的现象。图 7 展示了量化这些复杂系统的涌现行为的不同方法。

在上图 中,对两个 Boids 模拟之间的参数进行线性插值。这个中间模拟缺乏任一模拟的特征并且显得无序,表明了 boids 参数空间的非线性、混沌性质。重要的是,现在可以通过测量中间模拟的最终状态与两个原始模拟的 CLIP 相似性来为这种定性观察提供定量支持。

上图 则评估了粒子生命中粒子数量对其表示某些生命形式的能力的影响。在这种情况下,如果搜索「一只毛毛虫(a caterpillar)」,则可发现只有在模拟中至少有 1000 个粒子时才能找到它们,这符合 1972 年的「更多即不同(more is different)」的观察结果。

在上图中,通过单独扫描每个参数并测量 CLIP 提示词对齐分数的结果标准偏差,量化了粒子生命中每个模拟参数的重要性。在确定最重要的参数后,便对应上了绿色和黄色粒子之间的相互作用强度,这对于毛毛虫的形成至关重要。

上图 给出了对于 Lenia 模拟,CLIP 向量随模拟时间的变化速度。当模拟定性地看起来已成静态时,该指标恰好稳定,因此这可提供有用的模拟停止条件。
结语
值得一提的是,Sakana AI此前已经推出了“世界上首个用于自动化科学研究和开放式发现的AI系统”——AI Scientist(人工智能科学家)。该系统能够独立进行科学研究,无需人类插手,甚至能够一口气产出多篇学术论文。
这一研究成果一经发布便引起了广泛关注。许多人认为这是释放AI力量、重新定义人工生命的一项惊人工作。有研究者表示自己多年来一直在尝试类似的事,但Sakana AI的工作是一个更加精彩的版本。

此外,还有人提出疑问:这项研究是否可以用来观察意识的诞生?尽管目前还没有明确的答案,但毫无疑问,随着技术的发展,我们将逐渐揭开更多关于生命和意识的秘密。
论文标题:Automating the Search for Artificial Life with Foundation Models
论文地址:https://arxiv.org/pdf/2412.17799
在线论文:https://pub.sakana.ai/asal/
项目代码:https://github.com/SakanaAI/asal/
